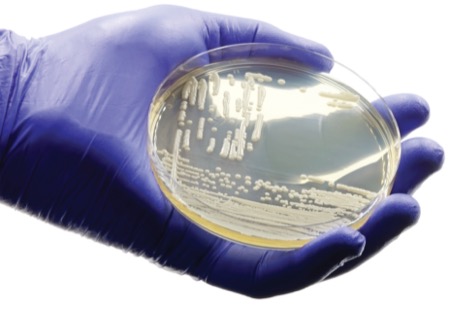

With Candida auris cases surging by more than 200% between 2019 and 2021 in the United States, this emerging multidrug-resistant (MDR) fungal pathogen has become a significant public health concern, according to the CDC. A recent Maryland study reveals that individuals and nursing facilities in low-income neighborhoods are bearing the brunt of the C. auris outbreaks.
“Neighborhood characteristics and socioeconomic disadvantage have been linked previously to COVID infections as well as methicillin-resistant Staphylococcus aureus infections, but this is the first study to look at how measures of socioeconomic vulnerability are related to the spread of C. auris,” said Leigh L. Smith, MD, MAS, an assistant professor of epidemiology and public health at the University of Maryland, in Baltimore.
Analysis of the first 140 C. auris cases among Maryland residents from June 2019 to December 2021 found that 41% of patients resided in severely disadvantaged neighborhoods. Many also had multiple comorbidities. “These patients tended to be very sick individuals with chronic medical conditions and tended to come from neighborhoods with less health insurance, lower socioeconomic status and high concentrations of racial and ethnic minorities,” Dr. Smith, primary study author, told Infectious Disease Special Edition.
The study found that nearly half of the Maryland patients were associated directly with skilled nursing facilities. These SNFs were disproportionately located in neighborhoods with higher levels of poverty and significant racial and ethnic minority populations.
“Responding to and preventing transmission of C. auris requires resources, staff and time, and facilities that are in socioeconomically disadvantaged neighborhoods have less staff and more financial strain,” Dr. Smith explained. “This can directly impact the ability of a facility to effectively implement infection control practices.”
Although good infection control is the mainstay of preventing the spread of MDR organisms in healthcare facilities, SNFs associated with C. auris transmission had poor hand hygiene, inconsistent access to cleaning supplies and insufficient education on appropriate cleaning protocols (Infect Control Hosp Epidemiol 2024 Jul 30. doi:10.1017/ice.2024.98).
Helping Vulnerable Neighborhoods
To combat C. auris outbreaks in vulnerable neighborhoods, Jacinda Abdul-Mutakabbir, PharmD, MPH, AAHIVP, an assistant professor of clinical pharmacy at the University of California, San Diego, emphasized the importance of managing medical conditions that are risk factors for acquiring C. auris or other MDR organisms.
“When we consider the pathophysiology of Candida infections, they are typically resultant of other unmanaged comorbidities or preexisting infectious disease states,” said Dr. Abdul-Mutakabbir, who is unaffiliated with the study. “If we work collaboratively to ensure that individuals have access to preventative resources, then we can work to address the inequities uncovered.”
She recommended integrating C. auris screening protocols for patients who report with suspected infectious illnesses and reside in socioeconomically deprived areas. She also stressed the importance of education in mitigating infectious diseases, since barriers to education due to socioeconomic factors contribute to their spread.
Policy interventions are necessary to address the financial and staffing strain of SNFs in socioeconomically disadvantaged neighborhoods, according to Dr. Leigh.
The sources reported no relevant financial disclosures.
This article is from the October 2024 print issue.